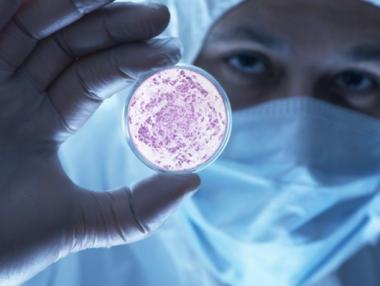

Бизнес
Bulgaria Air спря полетите си до Украйна
Националният превозвач Bulgaria Air преустановява полетите си между София и Одеса до 16 декември 2018 г. включително. Това обяви компанията, изтъквайки като причина обявеното военно положение в Украйна